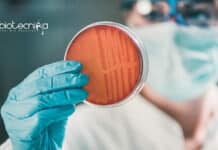
IIT Kanpur Antibiotic Resistance Project Recruitment – Assistant Vacancy IIT Kanpur Assistant Job

Test At Home’s Lollipop-Like Device For Covid Testing
Lollipop Based Covid Testing To Replace Nasal Swab Method
Here is a new alternative to the painful & annoying nasal swab tests for COVID-19. A...
Biotecnika Times Newsletter 14.10.2021 Govt National Centre for Disease Control Recruitment
Biotecnika Times - Govt National Centre for Disease Control Recruitment
Govt National Centre for Disease Control Recruitment - Download Biotecnika App to Apply
NCDC Lab Technician...
CSIR-IICT MSc Biotechnology Project Associate Recruitment, Attend Walk-In
CSIR-IICT MSc Biotechnology Project Associate Recruitment, Attend Walk-In
CSIR-IICT MSc Biotechnology Project Associate Recruitment, Attend Walk-In. CSIR Indian Institute of Chemical Technology Vacancies. Project Jobs...
Special Event: How Do Chromosomal Translocations Promote Cancer? A Talk Hosted By Biotecnika
Biotecnika FREE Webinar: How Do Chromosomal Translocations Promote Cancer?
“The influence of a good teacher can never be erased”
With this thought in mind, we invite...
AIIMS Bhubaneswar Research Assistant Recruitment, Applications Invited
AIIMS Bhubaneswar Research Assistant Recruitment, Applications Invited
AIIMS Bhubaneswar Research Assistant Recruitment, Applications Invited. MSc Molecular Biology, Genetics, Bsc & BTech Zoology, Biochemistry, Applied Biology...
MSc Life Sciences Project-SRF Recruitment at RCB, Apply Online
Project-SRF Life Sciences Job Opening at RCB, Apply Online
Project-SRF Life Sciences Job Opening at RCB, Apply Online. MSc Life Sciences Project Senior Research Fellow...
PGIMER Oral Cancer Project JRF Recruitment, Applications Invited
PGIMER Cancer Research Jobs - Biotech, Biochem, Life Sciences Apply
PGIMER Cancer Research Jobs - Biotech, Biochem, Life Sciences Apply. MSc Genetics/Life Sciences/Microbiology/ Biochemistry/Immunology/Biotechnology candidates...
ICMR-NIN Award of JRF Fellowship Leading to PhD, Applications Invited
ICMR-NIN JRF to PhD - Biochem/Biotech/Microbiology/ Mol Bio
ICMR-NIN JRF to PhD - Biochem/Biotech/Microbiology/ Mol Bio. MSc Biotechnology, Biochemistry, Microbiology and Molecular Biology Junior Research...
The Science of Happiness – Voice of Biotecnika
The Science of Happiness - Voice of Biotecnika
Voice of Biotecnika Podcast
Let’s imagine science has been successful to make us happy, yes I am talking...
ICMR Life Sciences Non-Medical Project Job With Rs. 56,660 pm Pay
ICMR Life Sciences Non-Medical Project Job With Rs. 56,660 pm Pay
ICMR Life Sciences Non-Medical Project Job With Rs. 56,660 pm Pay. MSc & PhD...
World’s First Malarial Vaccine To Be Produced By Bharat Biotech
Vaccine for malaria - Bharat Biotech and GSK to produce world’s first malarial vaccine
The Hyderabad-based vaccine company, Bharat Biotech will manufacture a part of the...
Govt National Centre for Disease Control Recruitment, Applications Invited
NCDC Lab Technician Jobs - Life Sciences, Biotech & Microbiology Apply
NCDC Lab Technician Jobs - Life Sciences, Biotech & Microbiology Apply. MSc Microbiology/ Life...
AIIMS Delhi Biotech, Biochem & Life Sciences JRF Recruitment
AIIMS Delhi Biotech, Biochem & Life Sciences JRF Recruitment
AIIMS Delhi Biotech, Biochem & Life Sciences JRF Recruitment. MSc Biotechnology, Biochemistry and Life Sciences Junior...
Covaxin Gets Nod For EUA For Use In Children
COVID Vaccine For Children - Covaxin gets EUA for children aged 2-18 years
The subject Expert Committee gave emergency use approval for administering the Covaxin...
CFTRI Biological Sciences Project Associate Job With Rs. 42,000 pm Salary
CFTRI Biological Sciences Project Associate Job With Rs. 42,000 pm Salary
CFTRI Biological Sciences Project Associate Job With Rs. 42,000 pm Salary MSc Biological Sciences....